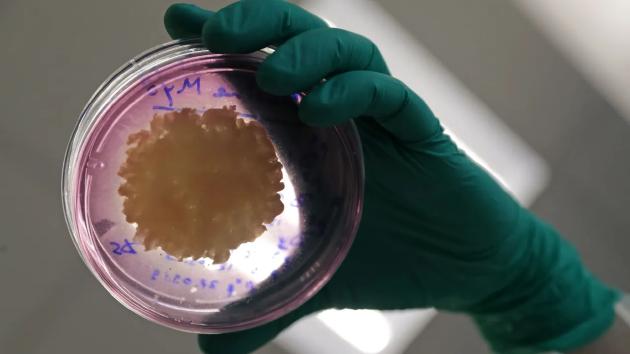
人造肉为什么比普通肉好吃,人造肉有什么特色

一些“素肉”看上去像肉一样,但这些植物替代品却品尝起来并不像肉,研究人员应该专注于复制肉,还是尝试制造新的、美味的替代品?
考虑到肉类行业对环境的影响,以及消费者对植物性食品日益增长的需求,人们可能会想我们是否很快为所有动物肉类产品提供素食替代品,近年来,研究人员花费大量精力进行尝试探索,从“血汁汉堡”到纯素鱼皮,一些新产品试图模拟吃肉的真实体验。
但是人造肉不仅仅口感和质地略差,还有什么需要完善的吗?有没有什么肉制品是永远无法被素食替代的?
或许最现实且不产生碳足迹的素肉方法是实验室里培育“人造肉”,这些人造肉是在实验室里从细胞培育而成的,这将比传统肉类使用更少的能源、土地和水,产生更少的温室气体排放,同时,这也是一个国际研究项目,许多科学家和研究机构都跻身于该领域。然而,即使是人工养殖的肉也距离真正肉制品有一段距离,更不用说实现商AAV业供应链。‘
第一批人工培育的肉制品是凝胶中生长的“非结构化”组织,其缺乏整块肉的纤维结构(它们甚至缺少生肉的血红色,这需要添加某些染料)。毕竟,整块肉不仅含有蛋白质,还含有脂肪、血管和结缔组织,在早期的细胞培养中产生的脂肪和肌肉细胞束更适于制作汉堡,相比之下使用人造肉制作的牛排口感略差一些。
目前越来越多的研究人员正在试验如何在实验室培育人造肉,且更具真实的肉质口感。2021年,日本大阪大学研究人员通过3D打印凝胶中的肌肉、脂肪和血管细胞,然后手工组装,最终培育出一种“和牛牛排”,完整的牛排长5毫米、宽10毫米。
日本和牛因其大理石般的肉质纹理而备受食客青睐,并且它含有高含量脂肪。正常情况下和牛的饲养条件需要消耗体能较少,且比其他品种的牛喂养的时间更长,从而才能达到所需的肉质高密度脂肪组织,人们品尝时会有一种特殊的黄油味。这个缓慢的生长过程,以及和牛受保护的生存环境,导致和牛的价格高居不下。虽然研究人员在实验室里培育出和牛肉,但是人造肉生产规模太小,而且当前制造成本太高,无法实现大规模生产。
尽管人造肉在生态可持续性方面占据优势,但人们通常并不将它视为一种纯素食。人造肉有两种制造方法:一是从动物尸体上提取肌肉组织,然后将其分离成肌肉卫星细胞、成体干细胞和多能干细胞;二是诱导动物细胞转化成为多能干细胞,并从中培养出新的细胞,培养细胞中的培养基也含有马血清(一种从马血中提取的免疫物质)。
即使人造肉被认为是纯素食,对于那些已放弃肉类或想要少吃肉的人群而言,它可能太令人反感了。对于35%荤食者和55%素食者来说,人造肉的“不自然”让人甚至不敢尝试。当人造肉被认为与肉类相似时,荤食者愿意品尝人造肉的比例将有所增加,但素食者却没有变化,他们对所有“肉类制品”保持拒绝态度。
我们能否在不使用任何动物产品的情况下,创造出类似和牛牛排等高价食材吗?素食替代品能像真实的素食一样颇受欢迎吗?

动物蛋白和植物蛋白的特征不同,例如:你仅需要想一下吃由豆类和鹰嘴豆制成的素食汉堡的经历即可,它们没有肉饼那种耐嚼、有弹性的口感,并且它们有点软。
很少有植物产品具有整块肉那些的纤维质地和耐嚼口感,但菠萝蜜是个例外,它未成熟时就像猪肉或者鸡肉一样肉质丰满,菠萝蜜是最受欢迎的素食肉类原料之一,但即使是这样,它也很难拼凑成一整块牛排,在烹饪的时候,植物和动物蛋白质也有不同的作用。
美拉德反应(Maillard reaction)是广泛存在于食品工业的一种非酶褐变,是羰基化合物(还原糖类)和氨基化合物(氨基酸和蛋白质)之间的反应,经过复杂的过程最终生成棕色甚至是黑色的大分子物质类黑精或称拟黑素,所以又称为“羰氨反应”。美拉德反应可使烹饪食物具有可口的气味和口感,并且产生肉质烹熟的棕色,虽然该反应不仅发生在肉制品中(还发生在酿造啤酒、咖啡和生产巧克力或者面包的过程中),但它在一定程度上解释了为什么烧烤或者外卖香味如此吸引人。
肉类香味来自于烧烤时释放的化合物,例如:噻唑或者噻吩,这些化合物可在植物中找到。
当食物被加热至高温状态时,其表面的氨基酸和糖会重新排列,从而释放出味道和香味化合物。蛋白质浓度越高,其释放的香味化合物就越多,糖浓度越高,释放出的香味化合物越多。温度以及水含量,是反应的关键因素,人们可以想象一下,将香肠烹饪至100摄氏度和在热烤架上稍微烤焦的区别,两种烹饪方式都是安全的,但仅有一种是真正吸引人的。
事实上,高温干燥烹饪(烘烤或者烧烤)时释放出来的噻唑或噻吩等化合物,也可以在植物中获得,其中一个例子就是2-甲基-3-噻吩硫醇,它会在烤肉中释放出来,但也存在于炒芝麻过程中。烘焙咖啡也会释放类似的化合物,但是植物芳香替代品很难找到。
为了从植物蛋白质中释放出同样的香味和味道,它们必须加热至高温状态。高温烹饪会降低所有食物的营养含量,尤其是动植物产品中所含的维生素B、C的含量。所以,植物性肉制品可能很美味,烧烤它们可能释放一些肉类香味,但它们不一样像制作普通蔬菜食材那样对人体健康有益。
动物脂肪具有独特属性,是植物脂肪难以复制的,例如:动物脂肪大多数是饱和性脂肪,这意味着它们在较高温度下会融化,而大多数植物脂肪在较低温度下会融化,仅有少数例外。
椰子油和棕榈油是其中的两个例外,它们经常被用于素食乳制品的替代品,但素食奶酪与大多数乳制品奶酪具有不同的口味和质地,软奶酪中的植物脂肪比硬奶酪的口感更好,而软奶酪、松软的切片汉堡奶酪之间的口感差别很小。

虽然素食奶酪替代品在质地方面已取得很大进步,但是其营养成分仍与乳制品存在一定差距,椰子油的饱和脂肪含量非常高,甚至比动物脂肪中所含饱和脂肪含量更高,如果不对素食乳制品(例如一些素食牛奶)增加营养成分,它们将缺少钙等营养物质。
人们使用乳制品的方式多种多样,可能会选择植物性替代品。人们日常生活中使用乳制品的途径和方式很多,一些方式并非直接显现出来的,可能会选择植物性替代品,并非纯乳制品,从冰淇淋到婴儿配方奶粉,许多食品都使用奶粉作为原料,而且采用植物进行代替可能更容易一些。
婴儿配方奶粉最常用原料是奶牛的牛奶蛋白质,这些蛋白质经过喷雾干燥后制成奶粉,当人们需要饮用牛奶时,可以用热水冲奶粉进行饮用。采用喷雾干燥工艺意味着奶粉可以保存更长时间,该状态可使奶粉的温度稳定且具有抗菌性,意味着牛奶制作成奶粉后更便于运输,不需要水分质量。
植物蛋白能取代婴儿配方奶粉中的牛奶蛋白吗?对于像婴儿配方奶粉这样的产品而言,常量营养元素(例如蛋白质和脂肪)和微量营养元素(例如维生素和矿物质)的适度平衡是非常重要的,生物化学家在寻找植物为基础的替代品时遇到一个困难——即如何保持奶粉的物理和营养特性。
植物蛋白代替牛奶蛋白的最大挑战是牛奶质地单一,都是源自奶牛,而对于植物蛋白而言,可以使用任何种类的植物蛋白,例如:即使采用豌豆或者蚕豆品种,它们也有不同的蛋白质谱。
就像科学家在人造鸡蛋中发现的那样,混合型豆类蛋白质可能是最佳解决方案,例如:豌豆中含有较高的人体必需氨基酸成分,它能与脂肪、水结合在一起,这意味着它们有助于牛奶乳化。与此同时,蚕豆富含豌豆中含量较少的蛋白质。
但是获得正确的蛋白质混合方法是一个挑战,植物蛋白颗粒通常更大,在油和水之间变得更厚,这意味着混合型植物蛋白的乳化效果远低于动物蛋白。
因此,完美制造人造肉产品仍有一段路要走,然而,我们有理由认为,我们可能很快就能在诸多食物中选择正确的植物替代品来取代动物性成分,我们可能还需要一段时间才能在超市看到植物性牛排,但这就是我们未来的目标吗?
我们不应该将研究重点放在植物性蛋白转化为肉类,而应该更多地关注如何将植物性蛋白制造地更好。这并不是一时的流行,人造肉不会消失,只是实现完美的肉类替代品需要很长一段路,未来我们将看到越来越多不同种类的产品,例如:人造猪肉、鸡肉、海鲜、牛肉,以及整块人造肉,科学家将一直致力于在该领域制造色香味俱全的人造肉。(叶倾城)